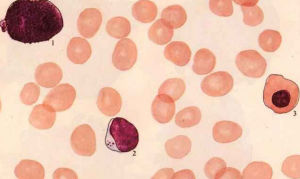
放射複合病

概述
被光輻射、衝擊波、早期核輻射和放射性沾染等引起的兩種以上(含)不同的損傷稱放射複合傷 (combined radiation injury) ,或稱放射複合病。放射複合傷是核戰爭和核事故中多見的傷類,在平戰時多種情況下也會發生複合傷。因傷情重、發展快、診治難,是傷亡的重要原因,故是救治的重要對象。放射複合傷的治療應重視:抗休克和保護心功能,早期外科處理和創傷促愈,控制感染和調節免疫;控制腸源性感染和恢復腸道功能;保護造血和促進造血重建,儘早套用抗輻射藥物。核武器的殺傷因素主有光輻射、衝擊波和核輻射。這三種因素在不同條件下的複合作用,會發生放燒沖複合傷、放燒複合傷和放沖複合傷。複合效應
 放射複合傷
放射複合傷由於核爆炸能量巨大,這些損傷本身已很重,一旦發生複合損傷,則傷情更加嚴重。一般有以下幾方面的重要複合效應:
1. 休克 放射損傷在複合其他損傷後可發生休克。如放射損傷合併燒傷時,常發生早期體克,成為早期死亡的重要原因。
2. 炎症和免疫 放射複合傷使免疫功能 ( 主要是細胞免疫 ) 低下,常早期發生嚴重感染,甚至導致早期服毒症。
3. 代謝 血漿蛋白減少、電解質紊亂、體重減輕等較單一傷類者為重。
4. 造血組織 造血功能受損貫穿於全過程,複合傷可能會加重造血組織的破壞。
5. 組織修復 組織修復延遲,傷口癒合不良。
病理
休克
 放射複合傷
放射複合傷在單純放射損傷時,早期休克是比較少見的。只有在受到很大劑量照射後,由於中樞神經系統和心血管系統的功能嚴重障礙,方可出現休克。而在放射複合傷時,休克發生率增加,程度加重。根據日本廣島、長崎傷員的調查資料,複合傷休克發生率為20%左右。嚴重的休克常是放射複合傷早期死亡的重要原因之一。放射複合傷時容易發生休克的可能因素有以下幾方面:
①受到致死劑量以上射線作用後,機體內出現一系列容易引起休克的改變,如中樞神經系統功能失調、血管反應性的改變、毛細血管的滲透性增加等等。再複合其它損傷後,由於二者的相互加重,使休克易於發生。
②燒傷、衝擊傷時的疼痛、失血、失液等能引起中樞神經系統功能失調、血液濃縮、循環障礙、組織乏氧以及電解質平衡失調,成為導致休克的重要因素。嚴重燒傷時,組織蛋白質凝固產生的毒性物質能作用於心血管,使血壓下降,也是促使休克發生的因素。
③複合傷時感染加重,特別在極期常發生敗血症,細菌毒素可引起中毒性休克。
感染
感染髮生率高,出現早、程度重。
 放射複合傷
放射複合傷感染在單純放射病、燒傷和衝擊傷中都比較突出,但複合傷時感染髮生更早、更多、更重。複合傷時發熱和感染灶開始時間均早於放射病。在極重度複合傷中,常見休克剛過,感染接踵而來,甚至休克期和感染期重迭,發生早期敗血症。在傷後2~3天內死亡者,心臟和脾臟等組織內均能培養出細菌。從感染在死亡原因中地位看,骨髓型放射病約有75%的動物主要死於感染,而相應劑量的放射複合傷,則約有90%主要死於感染。需強調指出,在實戰條件下,放射複合傷並發厭氧菌感染機會增多,傷情明顯加重,預後嚴重。
複合傷時感染加重的原因是:機體代謝紊亂,休克更為嚴重,全身抵抗力降低;單核吞噬系統吞噬功能抑制,白細胞數減少和功能降低,血清殺菌力下降、特異性和非特異性免疫功能減弱,從而使機體抗感染的細胞歷素和體液因素都受以更大的削弱。此外,燒傷創面、創傷傷口破壞了機體局部的屏障作用,壞死組織也成為利於細菌孽生繁殖的場所。細菌也可通過燒傷痂皮內的毛囊腔隙進入痂下,發生早期痂下感染。痂皮軟化溶解後,則更利於細菌的滋長和直接蔓延。
出血明顯
 放射複合傷
放射複合傷放射複合傷時,血小板數下降比單純放射病更快,也更低。在血小板數下降的同時,可見毛細管脆性增加和凝血障礙逐漸明顯。胃腸出血嚴重,胃腸黏膜常發生斑片狀出血。腸道有鉤蟲感染處出血更為嚴重。滲出的血液積留在腸壁,並從大便排出,形成血便,從而加重貧血的發生。出血處黏膜常陷於壞死,在此基礎上更易發生腸道感染。複合傷時,臨床出血症候群一般也比單純放射病提早出現,且更為嚴重。
複合傷的出血,早期主要是創傷、燒傷所致的血管通透性增高引起的創傷性出血;極期則主要是放射損傷所致的血小板顯著減少而引起的廣泛性出血。出血後不僅使全身喪失血量,而且使創傷、燒傷局部血液供應減少甚至斷絕,使組織離散。組織中的凝血還可為細菌滋生提供條件。
胃腸系統損傷明顯
放射複合傷時,由於小腸黏膜上皮,尤其是隱窩的幹細胞庫對射線十分敏感,故很容易受到破壞。大劑量照射後,小腸隱窩核分裂相消失,出現核壞死。未壞死的細胞核邊緣不清晰,核膜缺損,核扭曲。染色質間顆粒減少消失。絨毛各段上皮細胞壞死脫落。傷後2天,絨毛枯瘦,上皮細胞變矮、增寬。隱窩進行性破壞、崩解。隱窩和絨毛下部主要由畸形細胞構成。畸形細胞的異常核分裂,有的發生增殖死亡。腸上皮壞死細胞清除遲緩。小腸3H-TdR摻入率降低,小腸腸壁血循環障礙,腸壁各層淤血水腫明顯。有時由於腸蠕動增強等原因,可以並發腸套疊。腸套疊多發生於迴腸,一旦發生,將造成急性梗阻。在臨床上常表現出胃腸道功能紊亂。食慾減退、厭食、拒食、噁心、嘔吐、腹瀉等消化道症狀出現早、且嚴重。腹瀉常為水樣便或血水樣便。
造血器官損傷加重
放射複合病
放射複合病放射複合傷造血系統的變化以放射損傷的變化規律為主導。重度以上複合傷時,白細胞數傷後很快出現迅速下降,比單純放射病提早達最低值,最低值水平低、持續久。紅細胞初期升高,爾後進行性降低,貧血程度較單傷重,恢復較慢。
放射複合傷後,骨髓造血組織損傷明顯加重,造血細胞減少,造血組織幾乎全為脂肪細胞所代替。骨髓發生空虛的時間較相應劑量的單純放射病提前;放射複合傷時,粒系造血抑制主要是中幼粒細胞以前的具有分裂能力的粒系幼稚細胞受到抑制,並且較單純照射更為嚴重。放射複合傷貧血是大細胞低色素性的。此時骨髓幼稚紅細胞受到明顯抑制,紅系造血祖細胞受抑制出現早、恢復遲。放射複合傷貧血的原因,除紅系統造血抑制外,體內內環境可加速紅細胞破壞,使紅細胞的半生存期縮短。
放射複合傷時,除造血實質細胞受累外,造血微環境也受到明顯影響。傷後骨髓細胞貼壁率降低和骨髓基質祖細胞減少均較單傷明顯。放射複合傷傷後2天,造血組織及外周血中的核酸含量,無論是DNA或RNA,都有隨照射劑增加而顯著降低的趨勢。DNA較RNA減少更為明顯。
對創傷癒合的影響
放射複合傷時,燒傷和創傷局部改變的特點是:
(1)炎症反應減弱,局部白細胞浸潤減少,外觀表現創面滲出減少、乾燥、色暗、傷口收縮不良,壞死組織脫落遲緩。
(2)易並發感染,出血、組織壞死更加嚴重,甚至發生創面潰爛,壞死組織中可有大量細菌繁殖。
(3)燒傷、創傷和骨折的癒合時間推遲,肉芽組織形成不良,脆弱、蒼白、易出血。骨折時骨痂形成慢,容易發生假關節。
診斷
診斷放射複合傷可分別或同時複合有燒傷、衝擊傷、擠壓傷、火器傷等。這些損傷大多有體表表現,比較容易察覺,診斷的重點是明確有元放射損傷及其程度。首先應調查核爆炸的方式、當量、傷員當時所處的狀況 ( 距爆心的距離,防護情況等 ) ; 其次是根據傷員的表現判斷損傷部位。輔助檢查可發現白細胞總數、中性粒細胞和淋巴細胞三項數值均降低。淋巴細胞染色體畸變檢測可估計放射傷程度。治療
1. 早期救治 努力控制和消除各種可能誘發或加重休克的因素,並針對導致休克的主要原因進行救治。進行個人簡易防護,如戴口罩、圍毛巾、紮好袖口褲腳等,防止進一步沾染。
2. 積極抗休克,防治感染和出血。抗菌藥物使用應早期、適量和輪換選用。早期以抗革蘭陽性球菌為主,後其以抗革蘭陰性桿菌為主。
3. 早期使用抗放射藥物,如胱胺、半胱胺、 WR-2721 、雌激素類 ( 如雌三醇、炔雌醇及 523 片 ) 、中藥製劑 408 片等。還可套用阻吸收和促排泄的方法,如皮膚用鹽水、苯扎溴銨、擰橡酸鈉、 UIDA 等液沖洗;胃腸道選用含嗽、催吐或洗胃、導瀉或口服吸附沉澱劑 ( 氫氧化鋁、褐藻酸鈉等 ) ;呼吸道可用霧化吸入法、祛痰法等。促排出可用促排靈 (DTPA-Ca 、 Na) 、喹胺酸或疏基絡合劑,還應多飲水和用利尿劑。
4. 維持體液平衡和營養支持。可給予維生素 C 、維生素 B 12 、葉酸、人參銀耳製劑等促進造血再生;成分輸血糾正貧血或白細胞減少。
5. 若需手術治療,爭取在放射病極期以前完成手術處理,對沾染傷口套用剪刀 ( 勿用剃刀 ) 剪去其周圍毛髮,以等滲鹽水 ( 勿用乙醇 ) 徹底沖洗。進行清創,儘可能使之成為非沾染傷口。降低、調整麻醉藥物用量使傷員能耐受。
主要研究專家
 程天民
程天民程天民,中國工程院院士、第三軍醫大學軍事預防醫學系全軍複合傷研究所教授,中國防原醫學的主要開拓者和實踐者之一。2006年度,他一人獲得了首屆“重慶市科技突出貢獻獎”、第六屆“光華科技工程獎”和全國“優秀共產黨員”3項殊榮。文獻調查表明,國際上放射複合傷的研究論文中,60%來自程天民為學術帶頭人的科研團隊。中國上世紀90年代停止核試驗後,中國的防原醫學研究相對處於冷靜狀態,一些防原醫學研究機構轉行進行經濟效益更好的民用醫學研究。而就在這個時期,程天民“不合時宜”地提出了要加緊進行“複合傷”研究。 由他帶領的三醫大防原醫學教研室已成為國內唯一的主要研究複合傷的單位。他們進行的複合傷系列研究,獲得以國家科技進步一等獎為代表的一批重大成果,填補了國內多項空白。
